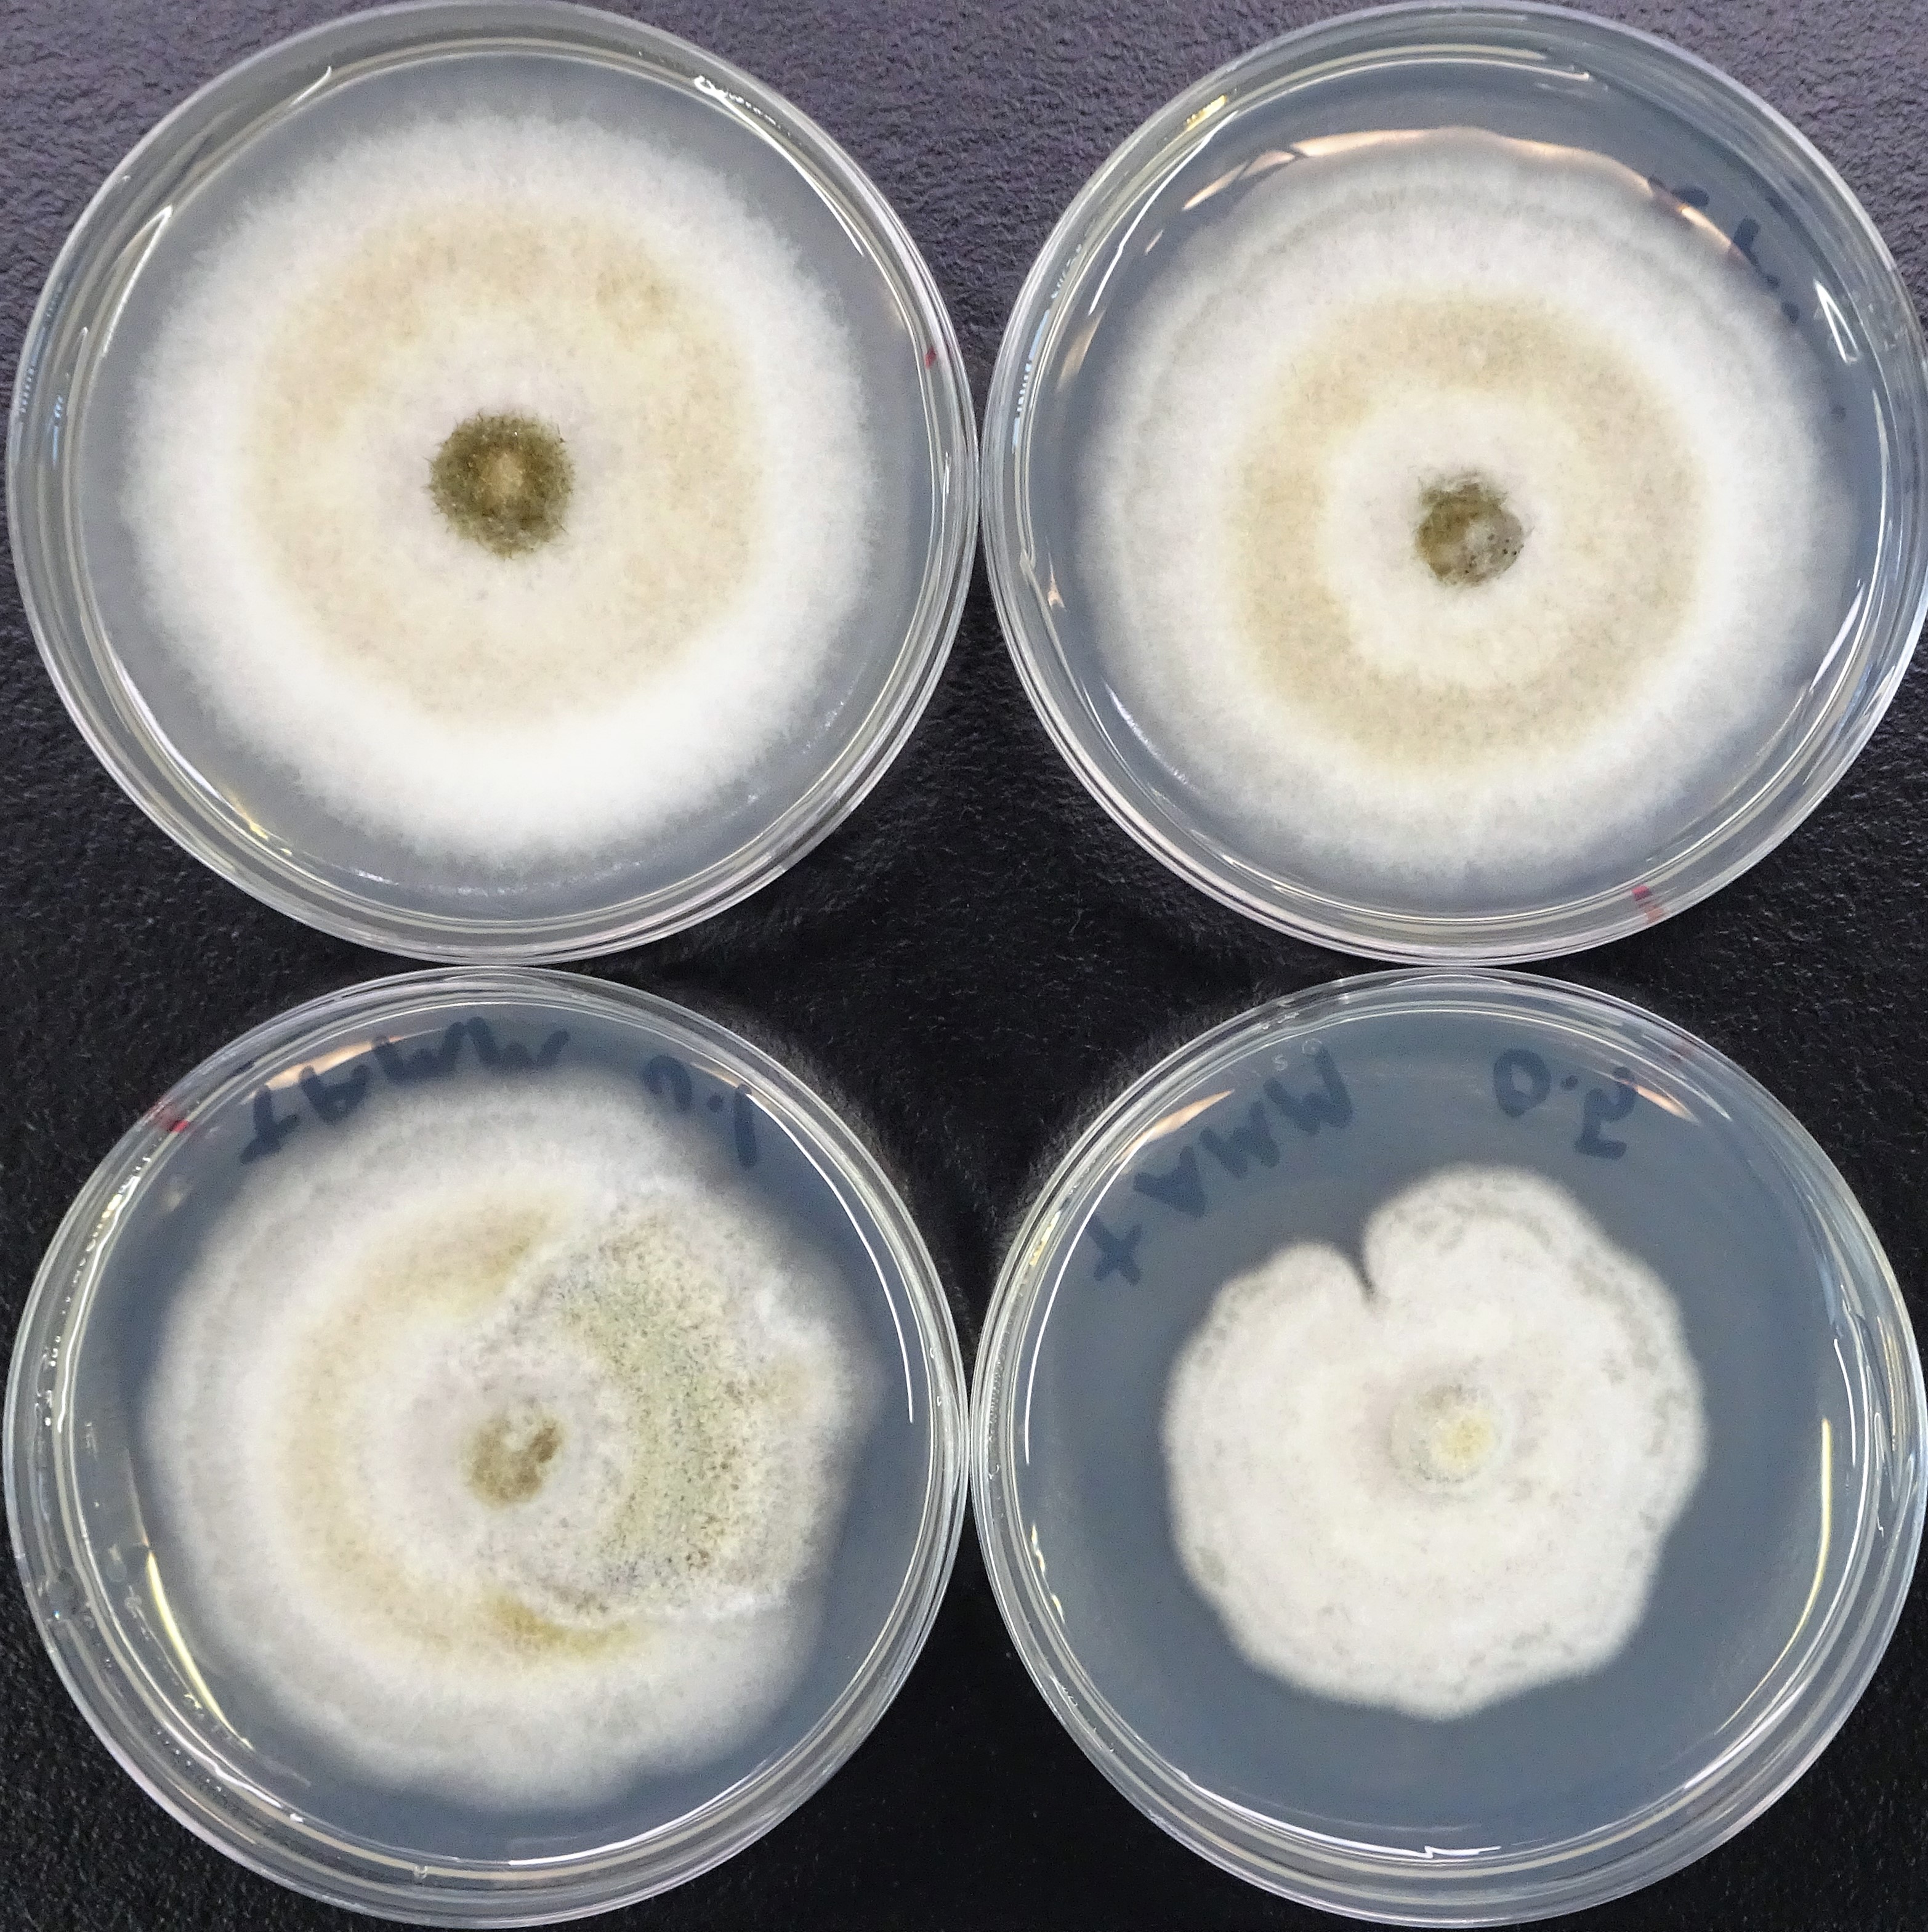
微生物（カビ）のプレート培養の一例（化合物処理による形態や色素生産の変化を探索）

入門ケミカルバイオロジー
入門ケミカルバイオロジー編集委員会(オーム社)
ケミカルバイオロジーとは、化学と生物学の境界領域にある、比較的新しい学問分野で、化学物質をスタートに生命の複雑な仕組みの理解に至る学問です。天然化合物を扱う天然物化学の分野や、創薬とも関連のある分野です。
この本は、生物学と化学とが密接に関係しており、生物学をより深く理解するには化学が不可欠であることを、科学的に重要な発見や身近な生命現象を例に挙げて説明しています。この本を通して、「生物は好きだけど化学は苦手」とか、「化学は勉強したけど、生物学はしていない」とかに関係なく、化学と生物学の境界にある科学を楽しんでもらいたいです。
有用な新規天然化合物を探す、誰も知らない「道具」を発見

薬のタネになる天然化合物を作る微生物
微生物の生産する天然化合物(分子量200~1,000程度の小分子化合物で、二次代謝物とも呼ばれます)は、ペニシリンやストレプトマイシン、アベルメクチンのように、医薬品や農薬として広く利用されてきました。
この地球上には未知の微生物が多くいます(身近な土の中からも新種を見つけることは割と簡単)。誰も調べたことのない微生物には、その働きを誰も知らない遺伝子があり、きっと新たな医薬・農薬のタネになる天然化合物を作る能力をもっているはずです。
新しい天然化合物は、探し方が鍵
最近では、新しい天然化合物を発見するのが困難になっています。他の人と同じ方法では、すでに他の人が見つけたものばかりを発見することになるので、探し方を工夫する必要があります。
土の中からあまり研究されていない糸状菌(カビ)を集めて探索源とする、というのが工夫の一つで、もう一つは、誰も使っていない「道具=酵素阻害剤」を使うことです。
鏡像異性体を作り分ける酵素を発見
私はこれまで、天然化合物の複雑な化学構造が「どうやって」作られるのかを調べる研究を行ってきて、非常に興味深い酵素を発見しています。Diels-Alder反応(大学の有機化学で絶対に習う、超有名な化学反応)を触媒する酵素で、私たちが発見した酵素は、同じ仲間だけど、鏡像異性体を作り分けることができます(構造生物学、天然物化学、有機化学、計算科学の専門家たちと共同で現在も、この謎「どうやって作り分けるのか」の解明にも挑んでいます)。
将来は欲しい化合物を作りたい
この酵素の研究の過程で、私たちは酵素阻害剤を発見しました。そして、この阻害剤を、新規化合物を探す「道具」とすることで、自分たちが欲しい化合物を効率的に見つけることができるようになりました。
同時に、生産菌のゲノム解読を進めることで、化合物とそれを作るための遺伝子をつなげていくことができ、将来的には、自在に、自分たちでデザインした遺伝子から化合物を作ることができるようになると期待しています。
微生物(カビ)の研究は、大学院博士課程になってから始めました。気がつけばそこからほぼずっとカビの研究をしています。前職の理化学研究所では、所属する研究室に多数の微生物が保有されており、自由に使うことが出来たので、何か上手く使えないかといろいろ培養したり分析したりする中で、あるカビに出会いました。
フォマセチンという化合物を高生産する特徴を持っていて、Diels-Alder反応を触媒する酵素の研究がこのカビを使うことで大きく発展しました。共同研究者にも恵まれ、研究論文や研究費獲得にもつながり、まさに、私を変えてくれた出会いでした。
「ゲノムマイニングと生合成酵素阻害剤処理を組み合わせた手法による新規化合物の探索」

| Q1.18才に戻ってもう一度大学に入るならば、学ぶ学問は? 化学、特に有機化学 |
|
| Q2.一番聴いている音楽アーティストは? YOASOBIの「群青」 |
|
| Q3.感動した/印象に残っている映画は? 『ロード・オブ・ザ・リング』 |
|
| Q4.学生時代に/最近、熱中したゲームは? 『ゼルダの伝説 ブレス オブ ザ ワイルド』(『ティアーズ オブ ザ キングダム』も・・・) |






